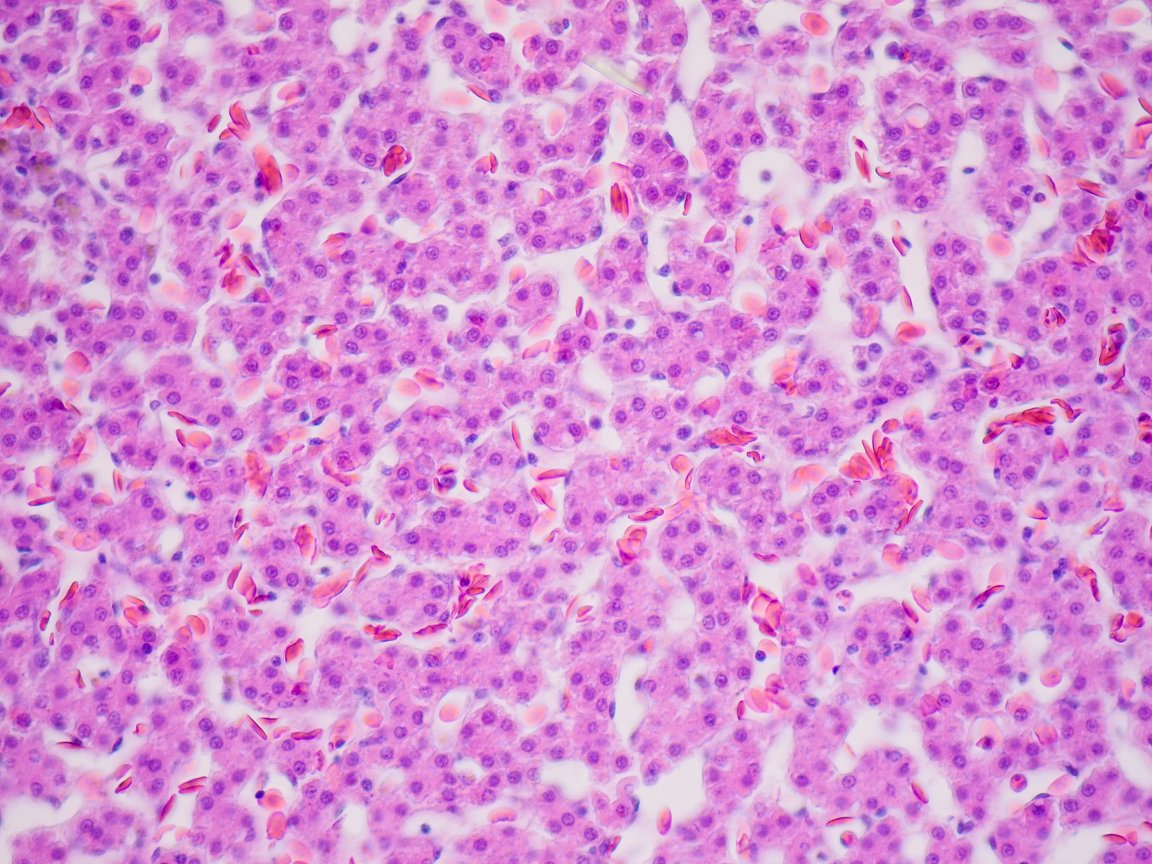
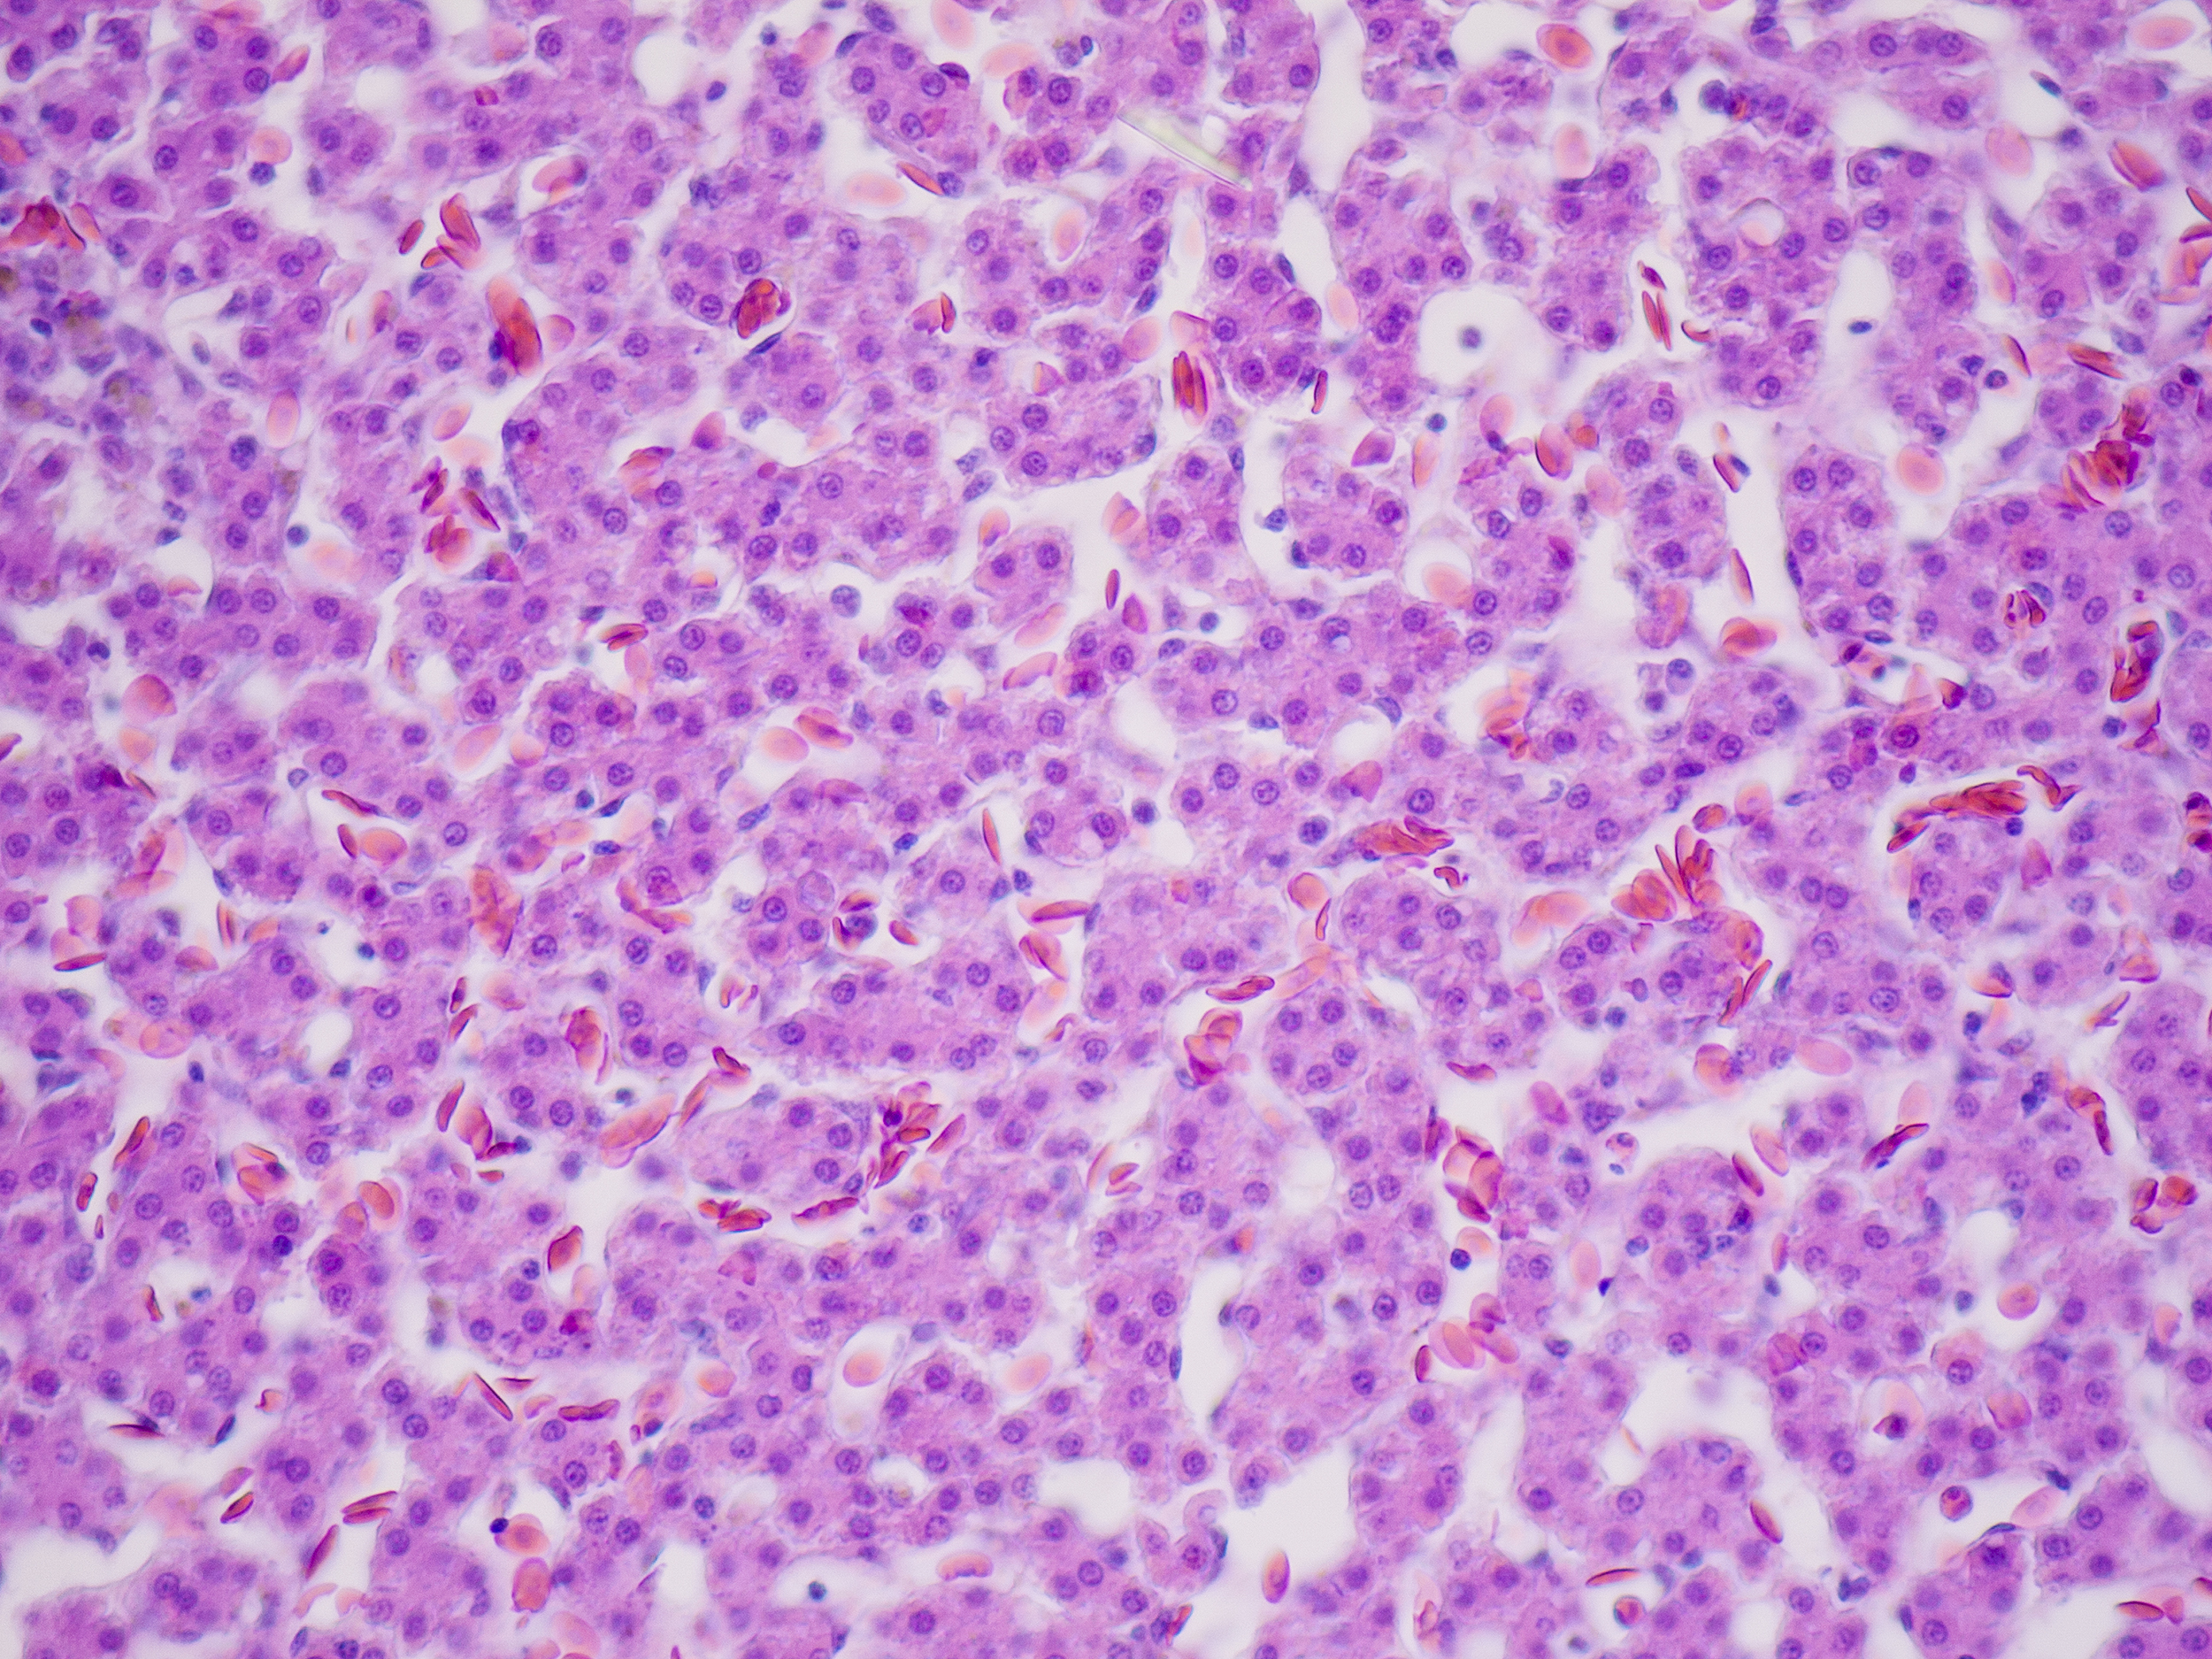

Safe and Effective
Out with the old, in with the new. That’s perhaps a good way to summarize the potential benefits of stem cell transplants in the growing field of aging research, which seeks to diminish or reverse age-related frailty in senior citizens. Two separate clinical trials involving the same stem cell transplant showed how the method is safe and exceptionally effective.
The results of both trials, published in The Journals of Gerontology, showed how a type of adult stem cell called mesenchymal stem cells (MSCs) could reverse the effects of aging. It’s the first kind of stem cell treatment specifically directed at age-related frailty.

The first trial involved 15 frail patients, each received single MSC infusion of stem cells collected from adult bone marrow donors aged between 20 and 45 years old. The patients exhibited improved overall quality of life and fitness, as well as diminished tumor necrosis factor levels. The second trial was a double-blind, randomized study involving a placebo group. Aside from noting no adverse effects, the research team found the improvements to be “remarkable.”
Promising Potential for Aging
Although both tests focused on proving how safe the MSC transplant method is, the results revealed how particularly effective it could be. In an accompanying guest editorial, David G. Le Couter noted the significance of the work. “Both studies are early-phase trials of a small number of participants, designed primarily to assess safety, so conclusions about efficacy need to be treated with caution. Even so, the results are striking and, at minimum, pave the way for large randomized Phase III clinical trials.”
Abundant research has been done to figure out ways to treat aging, a condition more doctors than ever are beginning to consider to be a disease that needs to be cured. Anti-aging research now includes well-funded initiatives from private companies, each determined to find the proverbial fountain of youth in a pill. Despite promising results, no treatment has yet received FDA approval — something the new stem cell method seems close to acquiring.
The researchers plan to move to an expanded clinical trial phase, with 120 patients from across 10 locations. Then, a final large randomized trial would follow, after which it would be possible to get approval for public use. “With the aging of the population, stem cells hold great promise to treat aging-related disability and frailty, improving physical capacity and quality of life,” researcher Joshua M. Hare, from the University of Miami Miller School of Medicine, said in a press release.